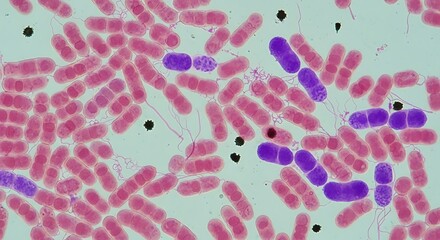
High magnification micrograph of anthrax bacteria infecting red blood cells.
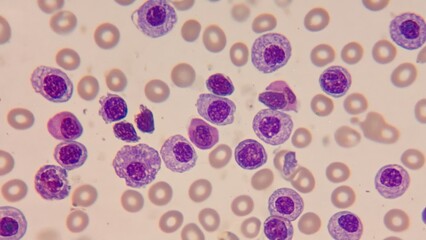
Microscopic view of human blood cells showing purple-stained white blood cells among red blood cells, representing hematology, medical research, laboratory diagnostics, biology, and cellular structure

- Home >
- Stock Photos >
- Microscopic View of Red Blood Cells Floating in Dark Background
Microscopic View of Red Blood Cells Floating in Dark Background Image

This detailed visualization of red blood cells illustrates components vital to human life. It is ideal for educational materials, healthcare publications, scientific research articles, and medical presentations that explore blood functions and circulation in the human body.
2
downloads
downloads
Tags:
More
Credit Photo
If you would like to credit the Photo, here are some ways you can do so
Text Link
photo Link
<span class="text-link">
<span>
<a target="_blank" href=https://pikwizard.com/photo/microscopic-view-of-red-blood-cells-floating-in-dark-background/664118fd122b469acbdd945515c895d0/>PikWizard</a>
</span>
</span>
<span class="image-link">
<span
style="margin: 0 0 20px 0; display: inline-block; vertical-align: middle; width: 100%;"
>
<a
target="_blank"
href="https://pikwizard.com/photo/microscopic-view-of-red-blood-cells-floating-in-dark-background/664118fd122b469acbdd945515c895d0/"
style="text-decoration: none; font-size: 10px; margin: 0;"
>
<img src="https://pikwizard.com/pw/medium/664118fd122b469acbdd945515c895d0.jpg" style="margin: 0; width: 100%;" alt="" />
<p style="font-size: 12px; margin: 0;">PikWizard</p>
</a>
</span>
</span>
Free (free of charge)
Free for personal and commercial use.
Author: People Creations
Similar Free Stock Images
Loading...